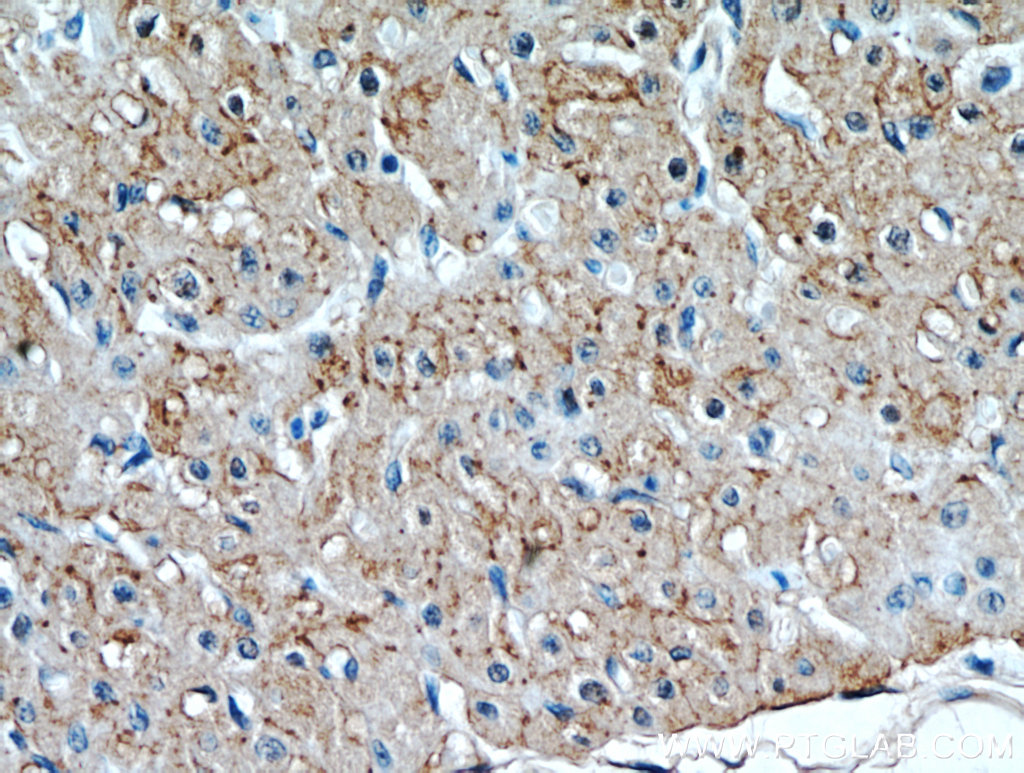

验证数据展示
经过测试的应用
| Positive WB detected in | HeLa cells |
| Positive IP detected in | mouse heart tissue |
| Positive IHC detected in | mouse heart tissue, human heart tissue Note: suggested antigen retrieval with TE buffer pH 9.0; (*) Alternatively, antigen retrieval may be performed with citrate buffer pH 6.0 |
| Positive IF-P detected in | mouse heart tissue |
| Positive IF/ICC detected in | HeLa cells |
推荐稀释比
| 应用 | 推荐稀释比 |
|---|---|
| Western Blot (WB) | WB : 1:500-1:2000 |
| Immunoprecipitation (IP) | IP : 0.5-4.0 ug for 1.0-3.0 mg of total protein lysate |
| Immunohistochemistry (IHC) | IHC : 1:50-1:200 |
| Immunofluorescence (IF)-P | IF-P : 1:50-1:500 |
| Immunofluorescence (IF)/ICC | IF/ICC : 1:50-1:500 |
| It is recommended that this reagent should be titrated in each testing system to obtain optimal results. | |
| Sample-dependent, Check data in validation data gallery. | |
产品信息
15386-1-AP targets Connexin-43 in WB, IHC, IF/ICC, IF-P, IP, CoIP, ELISA applications and shows reactivity with human, mouse, rat samples.
| 经测试应用 | WB, IHC, IF/ICC, IF-P, IP, ELISA Application Description |
| 文献引用应用 | WB, IHC, IF, IP, CoIP |
| 经测试反应性 | human, mouse, rat |
| 文献引用反应性 | human, mouse, rat, bovine |
| 免疫原 |
CatNo: Ag6698 Product name: Recombinant human Connexin 43 protein Source: e coli.-derived, PET28a Tag: 6*His Domain: 1-382 aa of BC026329 Sequence: MGDWSALGKLLDKVQAYSTAGGKVWLSVLFIFRILLLGTAVESAWGDEQSAFRCNTQQPGCENVCYDKSFPISHVRFWVLQIIFVSVPTLLYLAHVFYVMRKEEKLNKKEEELKVAQTDGVNVDMHLKQIEIKKFKYGIEEHGKVKMRGGLLRTYIISILFKSIFEVAFLLIQWYIYGFSLSAVYTCKRDPCPHQVDCFLSRPTEKTIFIIFMLVVSLVSLALNIIELFYVFFKGVKDRVKGKSDPYHATSGALSPAKDCGSQKYAYFNGCSSPTAPLSPMSPPGYKLVTGDRNNSSCRNYNKQASEQNWANYSAEQNRMGQAGSTISNSHAQPFDFPDDNQNSKKLAAGHELQPLAIVDQRPSSRASSRASSRPRPDDLEI 种属同源性预测 |
| 宿主/亚型 | Rabbit / IgG |
| 抗体类别 | Polyclonal |
| 产品类型 | Antibody |
| 全称 | gap junction protein, alpha 1, 43kDa |
| 别名 | GJA1, Connexin 43, GJAL, Gap junction alpha-1 protein, Gap junction alpha 1 protein |
| 计算分子量 | 43 kDa |
| 观测分子量 | 43-47 kDa |
| GenBank蛋白编号 | BC026329 |
| 基因名称 | Connexin-43 |
| Gene ID (NCBI) | 2697 |
| 偶联类型 | Unconjugated |
| 形式 | Liquid |
| 纯化方式 | Antigen affinity purification |
| UNIPROT ID | P17302 |
| 储存缓冲液 | PBS with 0.02% sodium azide and 50% glycerol, pH 7.3. |
| 储存条件 | Store at -20°C. Stable for one year after shipment. Aliquoting is unnecessary for -20oC storage. |
背景介绍
Connexin-43 (Cx43, also known as gap junction alpha-1), a connexin family member, plays an essential role in gap junction communication that facilitates direct communication among adjacent cells (PMID: 12270943). Usually, six connexin proteins oligomerize into a hemi-channel or connexon during intercellular channel formation (PMID: 12270943). Mutations of Cx43 may cause a series of diseases such as oculodentodigital dysplasia (ODDD), syndactyly 3 (SDTY3), hypoplastic left heart syndrome 1 (HLHS1) and so on (PMID: 18161618, 1472936, 1147490).
发表文章
| Species | Application | Title |
|---|---|---|
Nat Commun Single-cell analysis of murine fibroblasts identifies neonatal to adult switching that regulates cardiomyocyte maturation. | ||
Thromb Res Selective increase of cardiomyocyte derived extracellular vesicles after experimental myocardial infarction and functional effects on the endothelium. | ||
Hypertension Novel Role for the Immunoproteasome Subunit PSMB10 in Angiotensin II-Induced Atrial Fibrillation in Mice. | ||
Ecotoxicol Environ Saf Sodium Selenite inhibits mitophagy, downregulation and mislocalization of blood-testis barrier proteins of bovine Sertoli cell exposed to microcystin-leucine arginine (MC-LR) via TLR4/NF-kB and mitochondrial signaling pathways blockage. | ||
Environ Toxicol Pharmacol Microcystin-leucine arginine (MC-LR) induced inflammatory response in bovine sertoli cell via TLR4/NF-kB signaling pathway. | ||
Free Radic Biol Med Oxidative stress contributes to hepatocyte growth factor-dependent pro-senescence activity of ovarian cancer cells. |